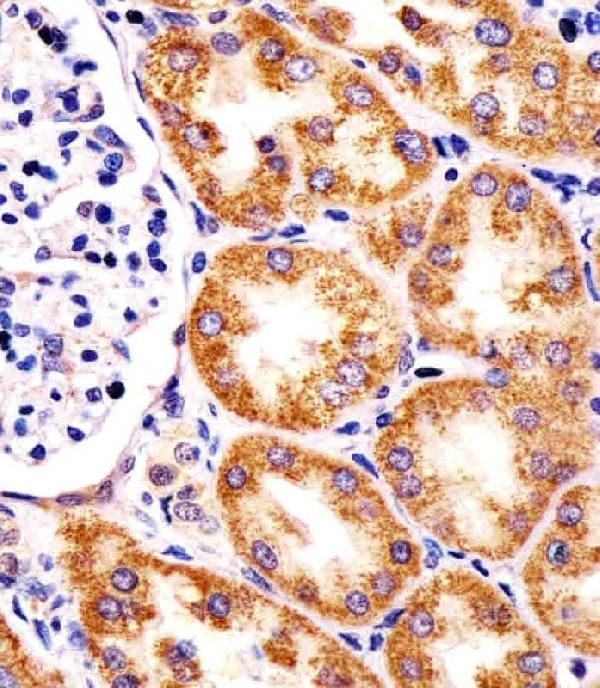
M00965 staining TST in human kidney tissue sections by Immunohistochemistry (IHC-P -paraformaldehyde-fixed, paraffin-embedded sections). Tissue was fixed with formaldehyde and blocked with 3% BSA for 0. 5 hour at room temperature; antigen retrieval was by heat mediation with a citrate buffer (pH6). Samples were incubated with primary antibody (1/25) for 1 hours at 37°C. A undiluted biotinylated goat polyvalent antibody was used as the secondary antibody.

All lanes : Anti-TST Antibody (Center) at 1:2000 dilution Lane 1: human liver lysate Lane 2: Hela whole cell lysate Lane 3: rat kidney lysate Lane 4: rat liver lysate Lysates/proteins at 20 microg per lane. Secondary Goat Anti-Rabbit IgG, (H+L), Peroxidase conjugated at 1/10000 dilution. Predicted band size : 33 kDa Blocking/Dilution buffer: 5% NFDM/TBST.
Anti-TST Antibody (Center)
M00965
ApplicationsWestern Blot, ImmunoHistoChemistry, ImmunoHistoChemistry Paraffin
Product group Antibodies
ReactivityHuman, Rat
TargetTST
Overview
- SupplierBoster Bio
- Product NameAnti-TST Antibody (Center)
- Delivery Days Customer9
- ApplicationsWestern Blot, ImmunoHistoChemistry, ImmunoHistoChemistry Paraffin
- CertificationResearch Use Only
- ClonalityPolyclonal
- Gene ID7263
- Target nameTST
- Target descriptionthiosulfate sulfurtransferase
- Target synonymsRDS, thiosulfate sulfurtransferase, epididymis secretory sperm binding protein, thiosulfate sulfurtransferase (rhodanese)
- HostRabbit
- IsotypeIgG
- Protein IDQ16762
- Protein NameThiosulfate sulfurtransferase
- Scientific DescriptionBoster Bio Anti-TST Antibody (Center) (Catalog # M00965). Tested in WB, IHC-P application(s). This antibody reacts with Human, Rat.
- ReactivityHuman, Rat
- Storage Instruction-20°C,2°C to 8°C
- UNSPSC12352203